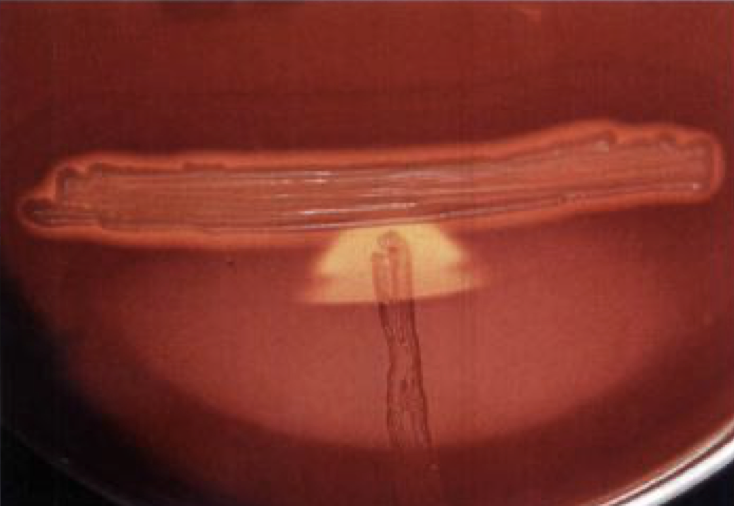
آزمایش camp

آزمایش CAMP چیست؟ آموزش کامل CAMP Test برای تشخیص استرپتوکوک گروه B
آزمایش CAMP یک تست کلاسیک در میکروبشناسی پزشکی است که با تکیه بر همولیز سینرژیستیک به شناسایی استرپتوکوک گروه B (Streptococcus agalactiae) کمک میکند. در این مقاله، اصل تست، روش انجام مرحلهبهمرحله، تفسیر نتایج، کنترل کیفی و نکات خطایابی به زبان ساده و کاملاً کاربردی توضیح داده شده است.
جهت عضویت در کانال آموزشی در تلگرام به لینک زیر مراجعه کنید:
https://t.me/hematology_education
فهرست مطالب (Table of Contents)
چرا آزمایش CAMP از نظر بالینی مهم است؟
اصل علمی آزمایش CAMP (Principle)
محیط کشت و مواد مورد نیاز
روش انجام آزمایش CAMP مرحلهبهمرحله
تفسیر نتایج آزمایش CAMP
کنترل کیفی آزمایش CAMP (Quality Control)
مزایا و محدودیتهای آزمایش CAMP
مقایسه آزمایش CAMP با تستهای مشابه
نکات مهم آزمایشگاهی
غربالگری بارداری و نقش آزمایش CAMP
جمعبندی
سوالات رایج درباره آزمایش CAMP
منابع معتبر برای مطالعه بیشتر
تعریف عفونتهای بیمارستانی و ارتباط آن با تشخیصهای آزمایشگاهی
عفونتهای بیمارستانی یا عفونتهای مرتبط با مراقبتهای سلامت (Healthcare-Associated Infections, HAIs) به عفونتهایی گفته میشود که معمولاً پس از بستری شدن یا دریافت خدمات درمانی ایجاد میشوند و قبل از ورود بیمار به مرکز درمانی وجود نداشتهاند. تشخیص بهموقع عوامل باکتریایی و اجرای دقیق تستهای شناسایی (از جمله آزمایشهای کلاسیک) میتواند در کنترل زنجیره انتقال، انتخاب درمان مناسب و کاهش پیامدهای HAIs نقش مهمی داشته باشد.
آزمایش CAMP چیست؟ (CAMP Test) | تست CAMP در میکروبشناسی پزشکی
تست CAMP (CAMP Test) یکی از تستهای کلاسیک بسیار مهم در بخش باکتریشناسی پزشکی (Medical Bacteriology) است که بهطور اختصاصی برای شناسایی استرپتوکوک گروه B یعنی Streptococcus agalactiae استفاده میشود.
این آزمایش بر پایه یک پدیده زیستی به نام همولیز سینرژیستیک (Synergistic Hemolysis) طراحی شده است؛ یعنی دو عامل همولیتیک ضعیف، وقتی در کنار هم قرار میگیرند، یک اثر همولیتیک قوی و قابل مشاهده ایجاد میکنند.
نام CAMP از حروف اول نام چهار محقق زیر گرفته شده است:
- Christie
- Atkins
- Munch-Petersen
چرا آزمایش CAMP از نظر بالینی مهم است؟ | اهمیت تشخیصی آزمایش CAMP
استرپتوکوک گروه B یکی از مهمترین پاتوژنهای فرصتطلب در انسان است که بهویژه در نوزادان، زنان باردار و سالمندان میتواند بیماریهای بسیار شدیدی ایجاد کند.
مهمترین عفونتهای مرتبط با این باکتری عبارتاند از:
- سپسیس زودرس نوزادی (Early-onset Neonatal Sepsis)
- مننژیت نوزادان
- پنومونی نوزادی
- عفونتهای دستگاه ادراری در زنان باردار
- عفونتهای خونی و پوستی در بزرگسالان
از آنجا که کلونیزاسیون واژینال GBS در مادران باردار شایع است، شناسایی دقیق این باکتری در آزمایشگاه نقش حیاتی در پیشگیری از مرگومیر نوزادان دارد. آزمایش CAMP یکی از ابزارهای کلیدی در این مسیر است.
برای مرور اصول پایه تشخیص باکتریها و مشاهده مورفولوژی، این مطلب را هم ببینید:
روش کار رنگ آمیزی گرم: اصول، روش و کاربردها
اصل علمی آزمایش CAMP (Principle) | همولیز سینرژیستیک (Synergistic Hemolysis)
اصل آزمایش CAMP بر اساس تعامل بیوشیمیایی دو عامل همولیتیک است:
1️⃣ β-لیزین (β-hemolysin) در آزمایش CAMP
این ماده توسط Staphylococcus aureus تولید میشود. بهتنهایی، β-لیزین اثر همولیتیک محدودی روی گلبولهای قرمز گوسفند دارد.
2️⃣ فاکتور CAMP (CAMP factor) در تست CAMP
این فاکتور یک پروتئین خارجسلولی است که توسط Streptococcus agalactiae ترشح میشود. بهتنهایی نیز قدرت همولیتیک بالایی ندارد.
🔗 اثر سینرژیستیک (Synergistic effect) در آزمایش CAMP
وقتی این دو عامل در نزدیکی هم قرار میگیرند:
- CAMP factor حساسیت غشای RBC را افزایش میدهد
- β-لیزین باعث لیز شدید RBC میشود
- نتیجه: همولیز واضح، مثلثی یا فلشمانند
این الگو امضای تشخیصی آزمایش CAMP محسوب میشود.
محیط کشت و مواد مورد نیاز آزمایش CAMP | Blood Agar و ابزارهای لازم
- Blood Agar (۵٪ خون گوسفند) → برای مشاهده دقیق الگوی همولیز
- سویه استاندارد Staphylococcus aureus β-همولیتیک → منبع β-لیزین
- کلنی مشکوک استرپتوکوک → ایزوله از نمونه بالینی
- انکوباتور ۳۵–۳۷°C → دمای ایدهآل رشد استرپتوکوکها
- لوپ استریل → جلوگیری از آلودگی متقاطع
روش انجام آزمایش CAMP (Step-by-Step) | اجرای تست CAMP در آزمایشگاه
- ابتدا یک خط مستقیم از Staphylococcus aureus در مرکز پلیت Blood Agar کشت دهید.
- کلنی مشکوک استرپتوکوک را بهصورت عمود بر خط استافیلوکوک کشت دهید.
- فاصله دو خط باید حدود ۲ تا ۳ میلیمتر باشد (نه تماس مستقیم، نه فاصله زیاد).
- پلیت را بهصورت وارونه در انکوباتور ۳۵–۳۷ درجه سانتیگراد قرار دهید.
- پس از ۱۸ تا ۲۴ ساعت، ناحیه اتصال خطوط را بررسی کنید.
نکته حیاتی: تماس مستقیم خطوط باعث نتیجه کاذب میشود.
تفسیر نتایج آزمایش CAMP | نتیجه مثبت و منفی CAMP Test
✅ نتیجه مثبت (Positive CAMP)
- مشاهده ناحیه همولیز پیکانی یا فلشمانند
- همولیز دقیقاً در محل نزدیکشدن دو خط کشت
- نشانه حضور Streptococcus agalactiae (گروه B)
❌ نتیجه منفی (Negative CAMP)
- عدم افزایش همولیز
- فقط همولیز معمول Blood Agar یا عدم همولیز
- رد GBS و احتمال سایر استرپتوکوکها
بعد از شناسایی عامل، آشنایی با تست حساسیت آنتیبیوتیکی کمک زیادی میکند:
دیسک آنتی بیوگرام: راهنمای جامع تست حساسیت آنتی بیوتیکی
کنترل کیفی تست CAMP (Quality Control) | QC در تست CAMP
کنترل کیفی تضمین میکند که:
- محیط کشت سالم است
- سویه استافیلوکوک مناسب است
- شرایط انکوباسیون درست بوده
کنترلها:
- کنترل مثبت: Streptococcus agalactiae
- کنترل منفی: Streptococcus pyogenes
عدم تطابق نتایج کنترلها = باطل شدن تست
نکته حرفهای: همیشه از استافیلوکوک β-همولیتیک واقعی (β-hemolytic) استفاده کنید.
برای اجرای حرفهایتر QC در بخش میکروب، این راهنما را از دست ندهید:
کنترل کیفی میکروب شناسی: اصول، روشها و استانداردهای عملکردی
مزایا و محدودیتهای آزمایش CAMP | Pros & Cons تست CAMP
✅ مزایا
- هزینه بسیار پایین
- آموزشمحور و قابل درک
- بدون نیاز به تجهیزات پیشرفته
- مناسب آزمایشگاههای با منابع محدود
❌ محدودیتها
- وابسته به مهارت کاربر
- احتمال خطای تکنیکی
- جایگزین تستهای مولکولی مانند PCR (Polymerase Chain Reaction) نیست
- برخی باکتریها واکنش شبهمثبت میدهند
مقایسه آزمایشتستCAMP با تستهای مشابه | CAMP vs Bacitracin vs Hippurate vs Latex
| تست | مکانیزم | کاربرد |
|---|---|---|
| CAMP | همولیز سینرژیستیک | تشخیص GBS |
| Hippurate | هیدرولیز هیپوریک اسید | تأیید GBS |
| Latex Test | آنتیژن لنسفیلد | تعیین گروه |
| PCR | ژنتیکی | تشخیص قطعی |
نکات مهم آزمایشگاهی در آزمایش CAMP | خطاهای رایج و پیشگیری
نکته آموزشی: خواندن زودهنگام یا دیرهنگام پلیت میتواند الگو را مخدوش کند.
نکته مهم: فقط از Staphylococcus aureus سویه β-همولیتیک استفاده شود؛ سویههای غیرهمولیتیک نتیجه را مخدوش میکنند.
نکته مهم: فاصله بیش از حد یا تماس مستقیم خطوط کشت میتواند باعث نتیجه کاذب شود. فاصله استاندارد ۲–۳ میلیمتر را حتماً رعایت کنید.
غربالگری بارداری و نقش تست CAMP | تشخیص GBS در زنان باردار
در بسیاری از کشورها، غربالگری GBS در هفتههای ۳۵–۳۷ بارداری انجام میشود. تشخیص سریع GBS با تستهایی مثل CAMP، امکان پروفیلاکسی آنتیبیوتیکی حین زایمان را فراهم میکند و بهطور چشمگیری مرگومیر نوزادان را کاهش میدهد.
جمعبندی نهایی | خلاصه کاربردی آزمایش CAMP
تست CAMP یک تست کلاسیک اما همچنان بسیار ارزشمند در میکروبشناسی پزشکی است. درک عمیق اصل تست، اجرای صحیح تکنیکی و تفسیر دقیق نتایج، این آزمایش را به یک ابزار تشخیصی قابل اعتماد برای شناسایی استرپتوکوک گروه B تبدیل کرده است.
سوالات رایج درباره آزمایش CAMP (FAQ)
1) آزمایش CAMP دقیقاً برای شناسایی چه باکتری استفاده میشود؟
آزمایش CAMP (CAMP Test) عمدتاً برای شناسایی استرپتوکوک گروه B یعنی Streptococcus agalactiae به کار میرود.
2) اصل تست CAMP چیست و چرا همولیز تقویت میشود؟
این تست بر پایه همولیز سینرژیستیک (Synergistic Hemolysis) است؛ تعامل فاکتور CAMP با β-لیزین باعث ایجاد همولیز واضح و فلشمانند میشود.
3) نتیجه مثبت تست CAMP چه شکلی است؟
نتیجه مثبت به صورت همولیز پیکانی/فلشمانند (Arrowhead-shaped hemolysis) در محل نزدیکشدن خطوط کشت دیده میشود.
4) چرا فاصله خطوط کشت در CAMP Test مهم است؟
اگر خطوط تماس مستقیم داشته باشند یا فاصله زیاد باشد، الگوی همولیز ممکن است درست تشکیل نشود و نتیجه کاذب ایجاد شود؛ فاصله استاندارد ۲–۳ میلیمتر توصیه میشود.
5) آیا هر سویهای از Staphylococcus aureus برای تست CAMP مناسب است؟
خیر؛ باید از سویه β-همولیتیک (β-hemolytic) استفاده شود، چون منبع β-لیزین لازم برای واکنش است.
6) کنترل مثبت و کنترل منفی در آزمایش CAMP چیست؟
کنترل مثبت: Streptococcus agalactiae و کنترل منفی: Streptococcus pyogenes است. اگر کنترلها درست نباشند، نتیجه تست معتبر نیست.
7) آیا تست CAMP جایگزین PCR میشود؟
خیر؛ PCR (Polymerase Chain Reaction) یک روش مولکولی با قدرت تشخیصی بالاتر است، اما CAMP یک روش کلاسیک ارزان و آموزشی است.
8) شایعترین خطاهای تکنیکی در تست CAMP چیست؟
سویه نامناسب استافیلوکوک، فاصله نامناسب خطوط، زمان/دمای انکوباسیون نادرست و خواندن دیرهنگام یا زودهنگام پلیت از خطاهای رایج هستند.
9) تست CAMP در چه شرایط بالینی بیشترین کاربرد را دارد؟
بهویژه در تشخیص GBS مرتبط با سپسیس و مننژیت نوزادی و نیز غربالگری زنان باردار کاربرد مهمی دارد.
10) چرا تشخیص GBS در بارداری مهم است؟
چون کلونیزاسیون واژینال GBS میتواند به انتقال به نوزاد منجر شود و با تشخیص، امکان پیشگیری (پروفیلاکسی) فراهم میشود.
منابع معتبر برای مطالعه بیشتر